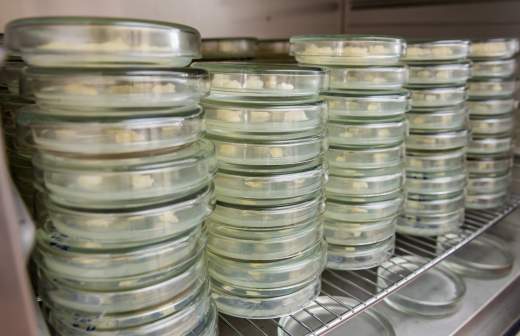

- Статьи
- Интернет и технологии
- Печать интеллекта: российские ученые объединили нейросети с 3D-принтерами
Печать интеллекта: российские ученые объединили нейросети с 3D-принтерами

Российские ученые разрабатывают программный комплекс на основе искусственного интеллекта для помощи инженерам-технологам при 3D-печати металлических изделий. ИИ-помощник поможет сократить материальные и временные затраты, обеспечит восстановление исправности деталей и снизит требования к квалификации пользователей специализированного оборудования. Эксперты считают, что технология может быть перспективной в таких областях, как машиностроение, автомобильная промышленность, авиация и металлургия. Однако некоторых специалистов смутило отсутствие конкретной специализации проекта.
Как сделать 3D-печать более эффективной
Ученые Центра компетенций НТИ «Цифровое материаловедение: новые материалы и вещества» МГТУ им. Н.Э. Баумана и и Дальневосточного федерального университета (ДВФУ) создают интеллектуального помощника для 3D-печати изделий. Отечественных аналогов у такого ИИ-помощника нет, специалисты объединили две современные технологии: нейросети и 3D-печать. У программного комплекса будет несколько задач: снижение требований к квалификации пользователей технологического оборудования, сокращение материальных и временных затрат, восстановление исправности деталей и другие аспекты применения.
— Технологии лазерного аддитивного производства металлических деталей признаны будущим обрабатывающей промышленности благодаря своим возможностям. Речь идет об изготовлении продукции сложных форм, значительном снижении массы изделий, сокращении материальных затрат и сроков производства прототипов. Однако существуют барьеры, затрудняющие активное применение аддитивных принципов изготовления металлических деталей в реальном производстве, — рассказал «Известиям» старший преподаватель Базовой кафедры фотоники и цифровых лазерных технологий Политехнического института ДВФУ Александр Никитин.
По его словам, сфера 3D-печати металлических изделий в настоящее время из-за большого количества факторов оказалась затратной по ресурсам и по времени. Одной из главных проблем считается нехватка квалифицированных кадров, связанная с высоким порогом входа в сферу, отметил эксперт.
— Используя ресурсы создаваемого программного комплекса, размещенного на облачной платформе IACPaaS, инженер-технолог будет вводить в программу информацию об оборудовании, материалах, необходимых для производства детали, а также ее технических характеристиках, установленных техническим заданием. Интеллектуальный ассистент, в свою очередь, сформирует рекомендации об оптимальном способе настройки параметров оборудования, — сообщил Александр Никитин.
Специалист отметил, что итоговым продуктом станет облачный сервис. Его практическая эксплуатация не потребует установки и настройки дополнительных программ на устройстве пользователя, будет необходим лишь персональный компьютер, планшет или смартфон с доступом к интернету. Как полагает эксперт, новая технология будет востребована на предприятиях в области авиастроения, машиностроения, автомобильной промышленности.
Он также уточнил, что работа в схожем направлении активно ведется также в таких странах, как Китай, США, Канада и Германия.
Какие риски связаны с ИИ-ассистентами
3D-печать металлических изделий требует просчета множества переменных. Каждая ошибка стоит значительных финансов, а область применения изготавливаемых деталей не терпит никаких просчетов: это касается и деталей для авиации, и теплонагруженных систем. Применение ИИ способно значительным образом снизить убытки от бракованных деталей. Нейросеть стоит тренировать в симуляторе печати, где он мог бы прогонять тысячи сценариев. А также сделать его персонализированным, чтобы он мог исследовать условия конкретного оборудования в конкретном цехе, считает директор Центра спортивного программирования, алгоритмической робототехники, кибербезопасности и киберспорта Уфимского университета науки и технологий Святослав Пегов.
— Аддитивные технологии — это одна из наиболее активно развивающихся технологий. Она применяется при быстром прототипировании конструкций и при опытном и мелкосерийном производстве. При этом существует множество параметров технологического процесса, которые необходимо учитывать при производстве изделий. При применении ИИ-помощника протипирование можно ускорить в разы, что существенно ускорит разработки новых изделий, поэтому разработка коллег актуальна на сегодняшний день и отвечает задачам, стоящим перед страной, — сказал заведующий лаборатории оптических технологий Центра компетенций НТИ «Фотоника» Глеб Шипунов.
Если ученым удастся создать удачный тандем из нейросетей и трехмерной печати, то это может стать массовой технологией не только для инженеров и не только для изделий из металла. Как только будут определены основные принципы, перенос опыта ИИ-советника на другие задачи 3D-производства будет уже не таким трудным, полагает IT-эксперт университета «Синергия» Алексей Ермаков.
— В таких областях, как машиностроение, автомобильная промышленность, авиация и металлургия, ИИ уже используется для прогнозирования износа оборудования, автоматизации производственных процессов, контроля качества и оптимизации цепочек поставок. Но стандартом для промышленности он пока не стал. В случае с разработкой НТИ пользователь сможет получать рекомендации по оптимальной настройке параметров, что снизит требования к их квалификации и позволит сократить время на эксперименты. Думаю, она сможет упростить жизнь инженерам за счет автоматизации сложных процессов настройки оборудования, — уточнил заместитель директора Центра компетенций НТИ «Технологии доверенного взаимодействия» на базе ТУСУР Руслан Пермяков.
По мнению ведущего эксперта Центра компетенций Национальной технологической инициативы «Искусственный интеллект» на базе МФТИ Александра Родина, в 3D-печати есть масса тонкостей, которыми технолог овладевает только с опытом. Однако в проекте его смущают глобальность и отсутствие специализации. Если продукт действительно полезный, его начнут использовать бесчисленные компании, производящие дроны и другую необходимую продукцию для фронта на самом неприхотливом оборудовании, уверен он.